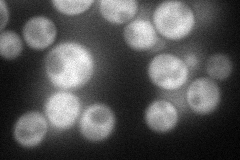
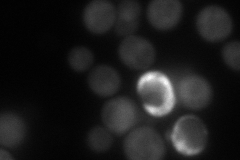
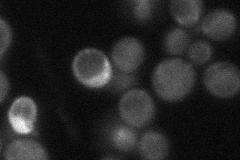
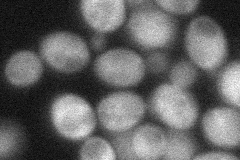

View description
Bifunctional enzyme with DRAP deaminase and tRNA:pseudouridine synthase activity; the deaminase catalyzes the third step in riboflavin biosynthesis and the synthase catalyzes formation of pseudouridine at position 32 in cytoplasmic tRNAs
Localization:
Intensity:
Fold change:
Significance:
-
C’ GFP library in SD

cytosol26.82 -
N' NOP1pr-GFP in SD
cytosol72.4735 -
N' TEF2pr-mCherry in SD
cytosol102.104 -
N' NATIVEpr-GFP in SD
cytosol34.9697 -
N' TEF2pr-VC and Cyto-VN in SD
cytosol53.0693 -
C’ GFP library in SD+DTT

cytosol30.251.12No -
C’ GFP library in SD+H2O2

cytosol28.981.08No -
C’ GFP library in Starvation Media

cytosol22.070.82No -
C’ GFP library on the background of Pup2-DaMP

cytosol -
C’ GFP library on the background of CCT mutant

cytosol31.89581.18901No
